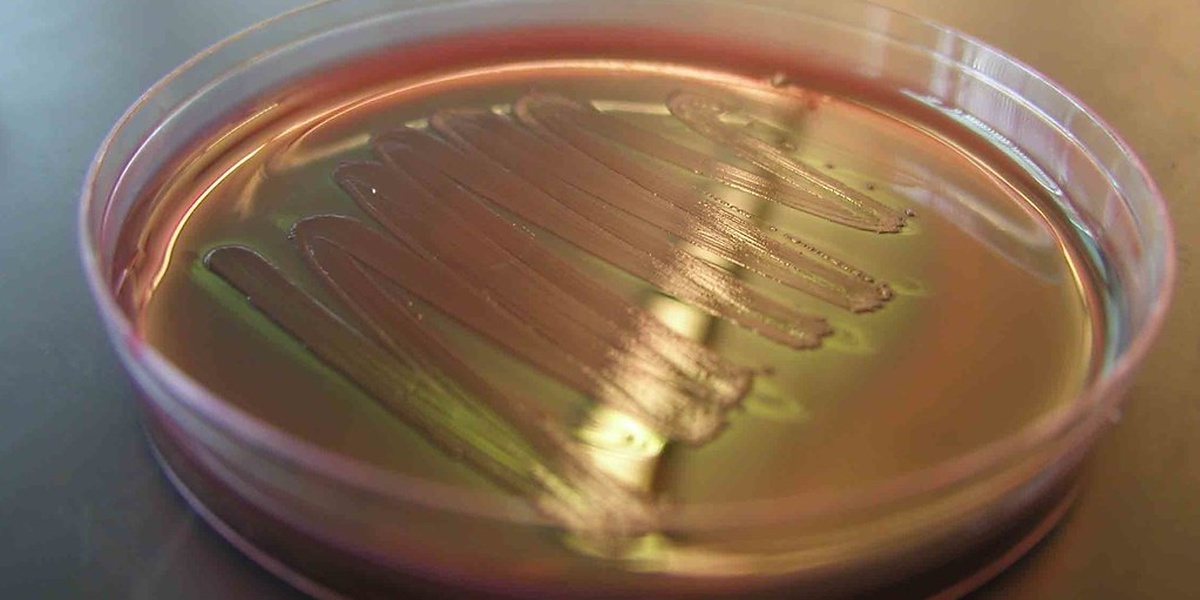
backup_image

From pond water to soil, single-celled life is everywhere, quietly doing work that supports larger ecosystems and sometimes affecting our health. Looking closely at these tiny organisms reveals a surprising range of forms and lifestyles that are easy to overlook at first glance.
There are 20 Examples of Unicellular Organisms, ranging from Amoeba proteus to Trypanosoma brucei, showing both free-living and parasitic strategies. Each entry is arranged to help comparisons, organized with Scientific name,Domain,Size (µm) so you can quickly scan classification and scale — you’ll find the full list and details below.
How do scientists tell these single-celled organisms apart?
Researchers use a mix of microscopy, staining, morphology and genetic sequencing: shape and size give initial clues, staining highlights structures, and DNA (or RNA) barcodes confirm species and relationships when appearance is ambiguous.
Are any of these unicellular organisms dangerous to people?
Some are harmless or beneficial, but a few are pathogens; for example, Trypanosoma brucei causes sleeping sickness in humans, while others may only affect plants or animals. Proper identification and context determine the actual risk.
Examples of Unicellular Organisms
| Name | Scientific name | Domain | Size (µm) |
|---|---|---|---|
| E. coli | Escherichia coli | Bacteria | 1-2 µm |
| Staphylococcus aureus | Staphylococcus aureus | Bacteria | 0.5-1 µm |
| Bacillus subtilis | Bacillus subtilis | Bacteria | 4 µm |
| Prochlorococcus | Prochlorococcus marinus | Bacteria | 0.6 µm |
| Synechococcus | Synechococcus sp. | Bacteria | 1 µm |
| Sulfolobus solfataricus | Sulfolobus solfataricus | Archaea | 1-3 µm |
| Halobacterium salinarum | Halobacterium salinarum | Archaea | 2 µm |
| Methanobrevibacter smithii | Methanobrevibacter smithii | Archaea | 1 µm |
| Baker’s yeast | Saccharomyces cerevisiae | Eukaryote | 5-10 µm |
| Paramecium | Paramecium caudatum | Eukaryote | 200-300 µm |
| Amoeba proteus | Amoeba proteus | Eukaryote | 500-1,000 µm |
| Plasmodium falciparum | Plasmodium falciparum | Eukaryote | 1-2 µm |
| Trypanosoma brucei | Trypanosoma brucei | Eukaryote | 15-30 µm |
| Giardia lamblia | Giardia lamblia | Eukaryote | 10-20 µm |
| Chlamydomonas | Chlamydomonas reinhardtii | Eukaryote | 10 µm |
| Euglena | Euglena gracilis | Eukaryote | 35-55 µm |
| Cryptosporidium | Cryptosporidium parvum | Eukaryote | 4-6 µm |
| Thalassiosira | Thalassiosira pseudonana | Eukaryote | 5 µm |
| Tetrahymena | Tetrahymena thermophila | Eukaryote | 50-60 µm |
| Mycoplasma genitalium | Mycoplasma genitalium | Bacteria | 0.2-0.3 µm |
Images and Descriptions

E. coli
Common gut bacterium found in humans and animals, typically 1-2 µm long. It lives in intestines and sewage, is a lab model and biotechnology workhorse, and includes benign strains as well as ones that cause foodborne illness and urinary infections.

Staphylococcus aureus
Round bacterium about 0.5-1 µm across that colonizes skin and nasal passages. Commonly harmless on people but can invade wounds or the bloodstream, causing skin infections, pneumonia or serious antibiotic-resistant infections like MRSA.

Bacillus subtilis
Rod-shaped bacterium roughly 4 µm long that lives in soil and plant surfaces. It forms resilient spores, serves as a model for studying bacterial physiology, and is used in industry for enzyme production and agricultural probiotics.

Prochlorococcus
Extremely small marine cyanobacterium about 0.6 µm across that dominates tropical and subtropical oceans. It produces large amounts of oxygen and fixes carbon, making it one of the most abundant photosynthetic organisms on Earth.

Synechococcus
Single-celled cyanobacterium around 1 µm in size common in oceans and freshwater. It contributes significantly to global photosynthesis, forms the base of many aquatic food webs, and adapts to a wide range of light and nutrient conditions.

Sulfolobus solfataricus
Acid-loving archaeon about 1-3 µm across found in hot, acidic springs. It tolerates high temperature and low pH, making it a model for extremophile biology and supplying enzymes useful for industrial processes that require heat resistance.

Halobacterium salinarum
Salt-loving archaeon typically around 2 µm long living in hypersaline lakes and salt pans. It uses retinal-based phototrophy to harvest light, colors salt ponds pink, and is studied for adaptations to extreme salinity and radiation.

Methanobrevibacter smithii
Common methanogenic archaeon roughly 1 µm in size that inhabits the human gut. It consumes hydrogen and produces methane, influencing digestion, gut ecology, and the overall balance of microbes in the intestinal microbiome.

Baker’s yeast
Also called baker’s or brewer’s yeast, typically 5-10 µm across and found on fruits, grains and in fermentation vats. It ferments sugars to alcohol and carbon dioxide, pivotal in baking, brewing and as a genetic model organism.

Paramecium
Ciliated protist about 200-300 µm long living in freshwater ponds and streams. It grazes on bacteria and algae, moves with coordinated cilia, and is a classic model for studying cell biology, behavior and basic physiology.

Amoeba proteus
Large free-living amoeba often 500-1,000 µm when extended, found in freshwater and moist soil. It engulfs prey by phagocytosis, produces crawling pseudopods, and is used to illustrate cell motility and single-cell feeding strategies.

Plasmodium falciparum
Single-celled malaria parasite roughly 1-2 µm in blood stages; it alternates between mosquitoes and human red blood cells. Responsible for severe malaria, it invades erythrocytes, evades immunity, and is a major global health concern.

Trypanosoma brucei
Flagellated protozoan about 15-30 µm long transmitted by tsetse flies in Africa. It causes sleeping sickness, evades the immune system through antigenic variation, and is notable for complex life stages in insect and mammalian hosts.

Giardia lamblia
Flagellated intestinal parasite roughly 10-20 µm long that causes giardiasis, a common waterborne diarrheal disease. It attaches to the gut lining, resists some environmental stresses, and spreads through contaminated water or person-to-person contact.

Chlamydomonas
Unicellular green alga about 10 µm in diameter living in freshwater. It swims with two flagella, performs photosynthesis, and serves as a model for studying flagellar motion, chloroplast biology and biofuel research.

Euglena
Flexible flagellate around 35-55 µm long found in freshwater. It can photosynthesize with chloroplasts or feed heterotrophically, making it a classic example of a mixotrophic protist adaptable to changing light and nutrient conditions.

Cryptosporidium
Protozoan parasite with oocysts about 4-6 µm that survives in water and causes cryptosporidiosis, a diarrheal illness. Resistant to chlorine disinfection, it spreads in contaminated water supplies and is a leading cause of waterborne disease outbreaks.

Thalassiosira
Unicellular diatom around 5 µm across that lives in marine and coastal waters. Encased in silica frustules, diatoms fix carbon efficiently, form large phytoplankton blooms and contribute substantially to global oxygen production and marine food webs.

Tetrahymena
Ciliated freshwater protist about 50-60 µm long commonly found in ponds. It feeds on bacteria, has separate germline and somatic nuclei, and is widely used in cell biology to study cilia, DNA processing and cellular signaling.

Mycoplasma genitalium
Tiny wall-less bacterium about 0.2-0.3 µm across that lives on mucous membranes, notably the human urogenital tract. With one of the smallest genomes of free-living organisms, it’s studied for minimal gene sets and causes some persistent infections.